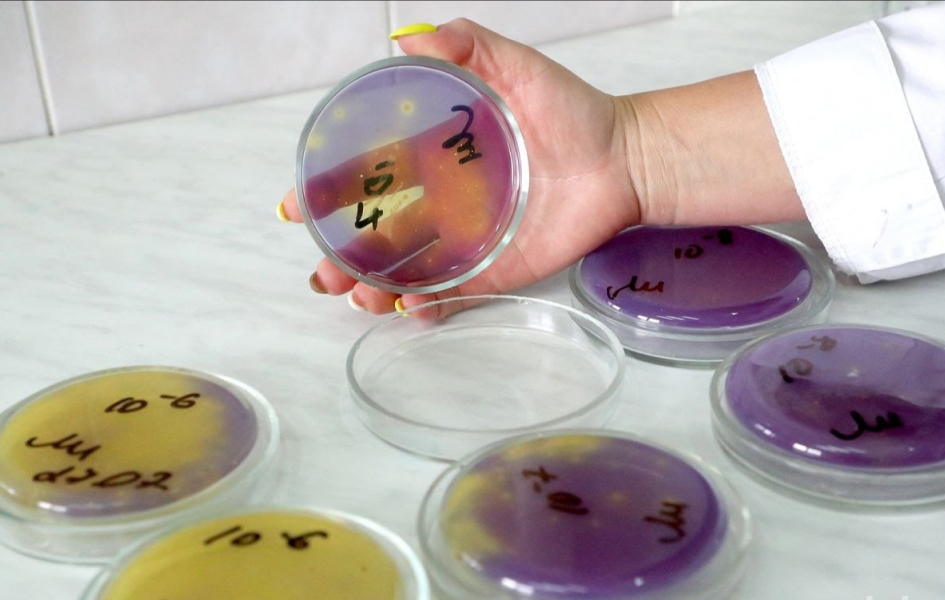

Институт мясо-молочной промышленности УП
Деятельность Института направлена на совершенствование и научное сопровождение молочной и мясной отрасли Республики Беларусь и включает следующие основные направления:
- Разработка новых видов мясных и молочных продуктов, ресурсо- и энергосберегающих, инновационных и импортозамещающих технологий производства молочной и мясной продукции.
- Разработка и совершенствование технологий производства бактериальных заквасок для молочной промышленности и биоконсервантов для АПК, продуктов функционального, специализированного, детского питания.
- Производство сухих и замороженных заквасок и биоконсервантов для перерабатывающей промышленности и АПК.
- Обеспечение функционирования и развития Республиканской коллекции промышленных штаммов заквасочных культур и их бактериофагов – национального достояния Республики Беларусь (Постановление Совета Министров от 19 декабря 2016 г. № 1043).
- Проведение испытаний сырья и готовой продукции по показателям качества и безопасности.
- Разработка гармонизированных с международными требованиями ТНПА, ТТИ, рецептур в области стандартизации и нормирования в мясной и молочной отрасли.
- Разработка новых технологий и средств санитарной обработки технологического оборудования и производственных помещений.
- Разработка современных организационно-экономических подходов и механизмов, направленных на повышение эффективности и конкурентоспособности мясной и молочной промышленности.
- Организация и проведение научно-практических мероприятий, обучающих курсов, направленных на повышение профессиональных навыков и знаний работников предприятий.
- Научно-технологическое сопровождение развития и модернизации мясной и молочной промышленности, оказание научно-методической и консультационной помощи.
На протяжении многих лет сотрудники Института работают над решением актуальных проблем мясной и молочной отраслей: разрабатываются и совершенствуются современные ресурсосберегающие технологии, формируются новые подходы к организации производства, создаются инновационные продукты на основе принципов здорового питания, в том числе детские и функциональные, проводится работа над нормативной базой.
Институтом реализовано множество проектов, имеющих значимость для всей страны с точки зрения расширения ассортимента продукции, улучшения качества и структуры питания населения, развития инновационных направлений, а также наращивания экспортного потенциала.
Институт находится во взаимодействии практически со всеми перерабатывающими предприятиями мясной и молочной промышленности. Осуществляется сотрудничество как в области разработки комплектов технической документации на производство определенного вида продукта, научного сопровождения при постановке новых видов продукции на производство и отработке технологических процессов, так и по выполнению исследований под конкретные потребности предприятий.
В своей деятельности мы стремимся эффективно сочетать науку и практику, создавая новые перспективные технологии и продукты, которые внедряются как на собственных производственных площадках, так и на перерабатывающих предприятиях отрасли.
Услуги компании
Все услуги компанииОказание услуг организациям и физическим лицам